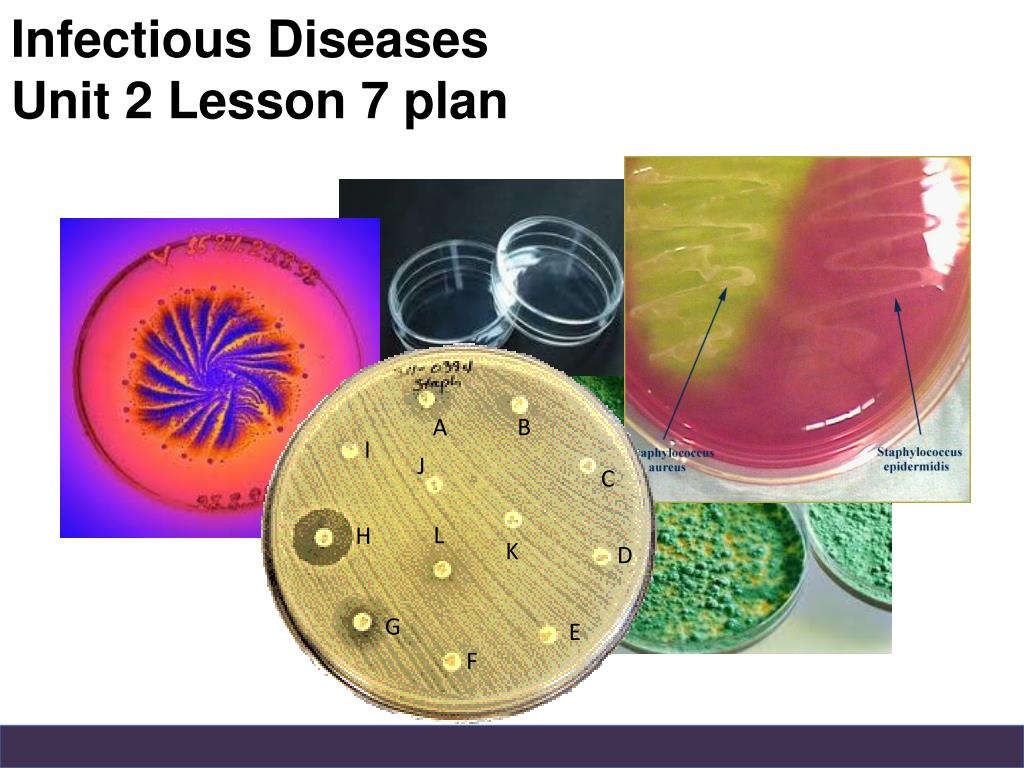
Unit 06 Human And Microbial Interaction Ppt Infectious Diseases

In addition to the information above, here is a curated collection of images related to Number Trace Worksheets Number Tracing Counting Writing Finding.
- Number Facts - Interesting Trivia & Information About Numbers
- What Is A Number ? - Youtube
- Number, Numbers - Learn How To Sign
- Number Academy The Encyclopedia Of Numbers
- Printable Number Chart